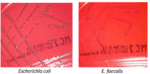

- Δίσκοι ευαισθησίας
- Προϊόντα ταυτοποίησης
- Χρωστικές
- Αναλώσιμα εργαστηρίου
- Αναλώσιμα αναλυτών
- Σωληνάρια αιμοληψιών
- Σωληνάρια αιμοληψιών κενού
- Σωληνάρια πλαστικά – πώματα
- Σύριγγες – βελόνες – πεταλούδες
- Αντικειμενοφόρες πλάκες – καλυπτρίδες – μικροαιματοκρίτες
- Πιπέτες Pasteur
- Πιπέτες Καθίζησης – Στατώ Καθίζησης
- Ρύγχη
- Τρυβλία
- Στυλεοί – κρικοφόροι
- Διαλύματα γλυκόζης
- Λάστιχο αιμοληψίας
- Παραφίλμ
- Strips
- Βαμβάκι
- Δοχεία απόρριψης βελονών
- Ουροδοχεία
- Θρεπτικά Υλικά
- Διάφορα αντιδραστήρια
MAC CONKEY AGAR No2 BIOPREPARE Φιαλίδιο 100 ml
Για την καλλιέργεια και ταυτοποίηση των εντεροβακτηριδίων και του Εντερόκοκκου.
ℹ️ Ελάχιστη Παραγγελία: 10 x 100 ml
ℹ️ Συσκευασία: 10 x 100 ml
⚠️ Οι τελικές τιμές επιβεβαιώνονται με την λήψη του προτιμολογίου και ενδέχεται να αλλάξουν χωρίς ειδοποίηση.
⚠️ Οι φωτογραφίες έχουν αποκλειστικά ενδεικτικό χαρακτήρα & ενδέχεται να διαφέρoυν από το πραγματικό προϊόν.
Reference Code: 060066
Κωδικός προϊόντος:
060066
Κατηγορίες: Θρεπτικά Υλικά, ΜΙΚΡΟΒΙΟΛΟΓΙΚΑ
Ετικέτα: ΦΙΑΛΙΔΙΟ 100ml
Περιγραφή
Το MAC CONKEY AGAR No2 είναι ένα θρεπτικό υλικό στο οποίο με την προσθήκη χολικών αλάτων Νο2 αναπτύσσεται (εκτός των εντεροβακτηριδίων) και ο Εντερόκοκκος.
Τα gram(-) αρνητικά εντεροβακτηρίδια που ζυμώνουν την λακτόζη, παράγουν κόκκινες ή ροζ αποικίες. Τα χολικά άλατα Νο 2 και το κρυσταλικό ιώδες αναστέλλουν την ανάπτυξη των gram(+) θετικών κόκκων εκτός του Εντερόκοκκου. Ο δείκτης ουδέτερο ερυθρό αλλάζει χρώμα με τη διάσπαση της λακτόζης.
ℹ️ ΧΡΟΝΟΣ ΖΩΗΣ: 365 ημέρες
ℹ️ ΦΥΛΑΞΗ : 2 – 25* C
Επιπλέον πληροφορίες
| Βάρος | 2 κ. |
|---|
Μεταφορικά
Για τα μεταφορικά επικοινωνήστε μαζί μας
Επικοινωνια
Σχετικά προϊόντα
BLOOD AGAR (HORSE BLOOD) BIOPREPARE Τρυβλίο 90 mm
Ένα υλικό που συνιστάται για την καλλιέργεια μιας μεγάλης ποικιλίας παθογόνων μικροοργανισμών. Τo υλικό αυτό παρασκευάζεται με την προσθήκη 5% αίματος αλόγου.
ℹ️ Ελάχιστη Παραγγελία: 10 x 90 mm ℹ️ Συσκευασία: 10 x 90 mm
⚠️Οι τελικές τιμές επιβεβαιώνονται με την λήψη του προτιμολογίου και ενδέχεται να αλλάξουν χωρίς ειδοποίηση. ⚠️Οι φωτογραφίες έχουν αποκλειστικά ενδεικτικό χαρακτήρα & ενδέχεται να διαφέρoυν από το πραγματικό προϊόν.
MUELLER HINTON AGAR BIOPREPARE Τρυβλίο 120 mm
Ένα μέσο για την αντιμικροβιακή δοκιμή ευαισθησίας στα αντιβιοτικά με τη μέθοδο διάχυσης του αντιβιοτικού από περιοχή μεγαλύτερης πυκνότητας σε περιοχή μικρότερης πυκνότητας (ζώνη αναστολής ανάπτυξης του μικροβίου).
ℹ️ ΧΡΟΝΟΣ ΖΩΗΣ: 150 ημέρες ℹ️ ΦΥΛΑΞΗ : 2 – 8* C
ℹ️ Ελάχιστη Παραγγελία: 5 x 120 mm ℹ️ Συσκευασία: 5 x 120 mm
⚠️Οι τελικές τιμές επιβεβαιώνονται με την λήψη του προτιμολογίου και ενδέχεται να αλλάξουν χωρίς ειδοποίηση. ⚠️Οι φωτογραφίες έχουν αποκλειστικά ενδεικτικό χαρακτήρα & ενδέχεται να διαφέρoυν από το πραγματικό προϊόν.
MUELLER HINTON AGAR BIOPREPARE Τρυβλίο 90 mm
Ένα μέσο για την αντιμικροβιακή δοκιμή ευαισθησίας στα αντιβιοτικά με τη μέθοδο διάχυσης του αντιβιοτικού από περιοχή μεγαλύτερης πυκνότητας σε περιοχή μικρότερης πυκνότητας (ζώνη αναστολής ανάπτυξης του μικροβίου).
ℹ️ ΧΡΟΝΟΣ ΖΩΗΣ: 150 ημέρες ℹ️ ΦΥΛΑΞΗ : 2 – 8* C
ℹ️ Ελάχιστη Παραγγελία: 10 x 90 mm ℹ️ Συσκευασία: 10 x 90 mm
⚠️Οι τελικές τιμές επιβεβαιώνονται με την λήψη του προτιμολογίου και ενδέχεται να αλλάξουν χωρίς ειδοποίηση. ⚠️Οι φωτογραφίες έχουν αποκλειστικά ενδεικτικό χαρακτήρα & ενδέχεται να διαφέρoυν από το πραγματικό προϊόν.
Βαμβάκι COTONI σε Ρόλο για Νοσοκομεία – Κλινικές
Παράγεται από 100% υδρόφιλο φαρμακευτικό βαμβάκι. Πληροί τις προδιαγραφές τις Ελληνικής Φαρμακοποιίας και φέρει σήμανση CE.
ℹ️ Διαθέσιμες ποσότητες : 500gr - 800gr - 1000gr
Επιλογή
Αυτό το προϊόν έχει πολλαπλές παραλλαγές. Οι επιλογές μπορούν να επιλεγούν στη σελίδα του προϊόντος
Βαμβακοφόροι εντός σωληναρίου με υλικό μεταφοράς Stuart
Βαμβακοφόροι στυλεοί πλαστικοί, με rayon, μήκους 150mm, εντός πλαστικού σωληναρίου διαστάσεων 150Χ12mm με υλικό μεταφοράς STUART, με ετικέτα αναγραφής στοιχείων, αποστειρωμένοι, συσκευασμένοι ανά ένας σε blister.
ℹ️ Ελάχιστη Παραγγελία: 20 ℹ️ Συσκευασία: 150
⚠️Οι τελικές τιμές επιβεβαιώνονται με την λήψη του προτιμολογίου και ενδέχεται να αλλάξουν χωρίς ειδοποίηση. ⚠️Οι φωτογραφίες έχουν αποκλειστικά ενδεικτικό χαρακτήρα & ενδέχεται να διαφέρoυν από το πραγματικό προϊόν.
Βαμβακοφόροι στυλεοί ξύλινοι, 150mm, αποστειρωμένοι ανά ένας
Βαμβακοφόροι στυλεοί ξύλινοι, 150mm, αποστειρωμένοι ανά ένας , σε ατομική συσκευασία blister.
ℹ️ Ελάχιστη Παραγγελία: 100 ℹ️ Συσκευασία: 100
⚠️Οι τελικές τιμές επιβεβαιώνονται με την λήψη του προτιμολογίου και ενδέχεται να αλλάξουν χωρίς ειδοποίηση. ⚠️Οι φωτογραφίες έχουν αποκλειστικά ενδεικτικό χαρακτήρα & ενδέχεται να διαφέρoυν από το πραγματικό προϊόν.
Πεταλούδες αιμοληψίας Fly/Set RAYS Ιταλίας
Πεταλούδα αιμοληψίας Fly/Set , μιας χρήσης, αποστειρωμένη, ανοξείδωτο χάλυβα AISI 304, με τριπλή πλαγιοτομή, μη τοξικό και μη πυρετογόνο. Ατομική συσκευασία blister.
ℹ️ Ελάχιστη Παραγγελία: 100 ℹ️ Συσκευασία: 100
⚠️Οι τελικές τιμές επιβεβαιώνονται με την λήψη του προτιμολογίου και ενδέχεται να αλλάξουν χωρίς ειδοποίηση. ⚠️Οι φωτογραφίες έχουν αποκλειστικά ενδεικτικό χαρακτήρα & ενδέχεται να διαφέρoυν από το πραγματικό προϊόν.
Επιλογή
Αυτό το προϊόν έχει πολλαπλές παραλλαγές. Οι επιλογές μπορούν να επιλεγούν στη σελίδα του προϊόντος
Σύριγγες Rays InJ/Light ® Ιταλίας Χωρίς Βελόνα
Σύριγγα RAYS InJ/Light ® Ιταλίας χωρίς βελόνα, Διάφανο πολυπροπυλένιο, μη τοξικό και μη πυρετογόνο, αποστειρωμένη, μιας χρήσης. Ατομική συσκευασία blister .
ℹ️ Ελάχιστη Παραγγελία: 100 τεμ.(1ml – 3ml – 5ml – 10ml) ℹ️ Ελάχιστη Παραγγελία: 50 τεμ.(20ml) ℹ️ Ελάχιστη Παραγγελία: 20 τεμ.(60ml) ℹ️ Το προιόν διατίθεται σε : 1 ml , 3ml , 5ml, 10ml, 20ml, 60ml.
Επιλογή
Αυτό το προϊόν έχει πολλαπλές παραλλαγές. Οι επιλογές μπορούν να επιλεγούν στη σελίδα του προϊόντος